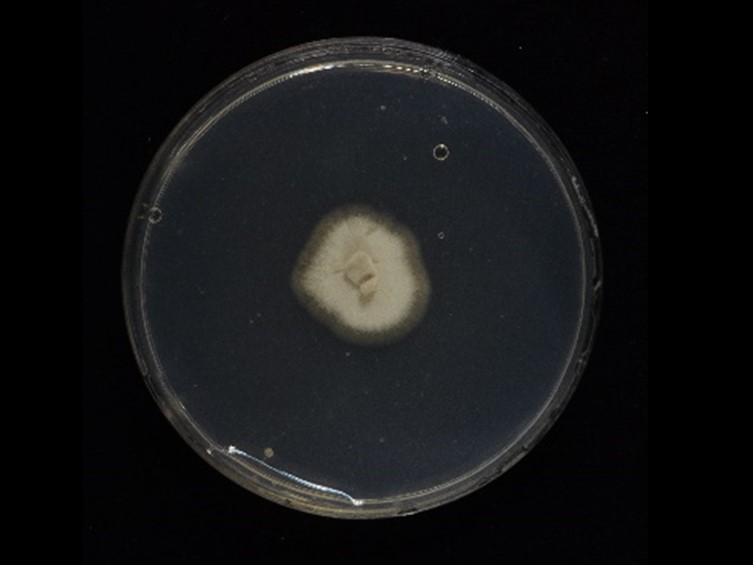

Holotype:
THAILAND, Nakhon Si Thammarat Province, Khao Luang National Park, 26 Jan. 2016, K. Tasanathai, S. Mongkolsamrit, D. Thanakitpipattana, W. Noisripoom, R. Promharn, P. Srikitikulchai, S. Wongkanoun, holotype BBH 41240, ex-type living culture BCC 80733.
Habitat:
Underside of leaves.
Host:
Cricket adults (Gryllidae).
Description:
Scant mycelium covering the  host body, flattened, tomentose, white to cream.
host body, flattened, tomentose, white to cream.  Perithecia superficial, pale cream, ovoid to obclavate, 220-280 × 130-170 μm.
Perithecia superficial, pale cream, ovoid to obclavate, 220-280 × 130-170 μm.  Asci cylindrical with thickened ascus apex, 8-spored, 125-162.5 × 9.5-15 μm. Ascus cap rounded.
Asci cylindrical with thickened ascus apex, 8-spored, 125-162.5 × 9.5-15 μm. Ascus cap rounded.  Ascospore filiform, multi-septate, not disarticulating into partspores, 68-87.5 × 4-5 μm.
Ascospore filiform, multi-septate, not disarticulating into partspores, 68-87.5 × 4-5 μm.
Culture characteristics:
Colony on PDA slow-growing, attaining ca 1.2 cm diam after 30 d at 20 °C, white cream, cottony with high mycelial density, pigmented around the colony. Colony reverse cream yellow. Colony on PDA did not produce any conidiogenous structures after 1 mo. Chlamydospores observed on PDA after 1 mo.
Colony on PDA slow-growing, attaining ca 1.2 cm diam after 30 d at 20 °C, white cream, cottony with high mycelial density, pigmented around the colony. Colony reverse cream yellow. Colony on PDA did not produce any conidiogenous structures after 1 mo. Chlamydospores observed on PDA after 1 mo.
Reference:
Thanakitpipattana D, Tasanathai K, Mongkolsamrit S, et al. (2020). Fungal pathogens occurring on Orthopterida in Thailand. Persoonia 44: 140–160.
DOI: https://doi.org/10.3767/persoonia.2020.44.06Species |
Strain |
Compound |
Pubchem CID |
Biological activity |
Reference |
|---|
|
Strain |
LSU | RPB1 | RPB2 | SSU | TEF1 |
|---|---|---|---|---|---|
| BCC 39684 | MK632096 | MK632181 | MK632148 | MK632122 | MK632071 |
| BCC 80733 | MK632097 | MK632176 | MK632149 | MK632121 | MK632072 |